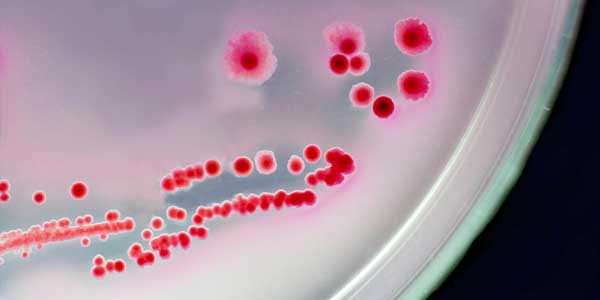
البكتيريا النافعة by adel - Ourboox.com

مقدمة
موضوع الدرس عن البكتيريا النافعة للصف الخامس الأبتدائي سوف اعرض فيديو وشرح وصور عن موضوع البكتيريا ومسبباتها ومميزاتها ونشأتها وطرق حركتها
.
Copyright © 2018
.


ما هي البكتيريا النافعة ؟
هي نوع من البكتيريا تتواجد داخل الجسم بكثرة وخاصةً في الجهاز الهضمي، وتتواجد أيضاً في الفم والأنف والحلق وعلى الجلد كما تتواجد في المهبل والرحم عند النساء، ويمكننا الحصول عليها من بعض الأطعمة مثل الألبان ومشتقاتها، وتقوم هذه البكتيريا بدورٍ رئيسي في هضم الطعام والقيام بعمليات حيوية مختلفة، كما يكون لها دور مهم في مقاومة وعلاج بعض أمراض الجهاز الهضمي.
https://mawdoo3.com/%D9%85%D8%A7_%D9%87%D9%8A_%D8%A7%D9%84%D8%A8%D9%83%D8%AA%D9%8A%D8%B1%D9%8A%D8%A7
موقع درس البكتيريا وصورها

Published: Jul 23, 2018
Latest Revision: Aug 4, 2018
Ourboox Unique Identifier: OB-511914
Copyright © 2018
